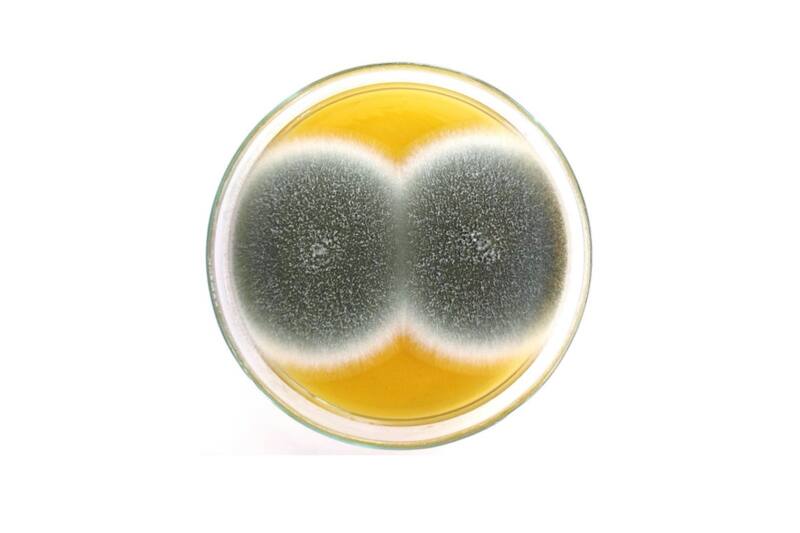

Preocupación genera nuevamente el COVID-19. Esto porque se registró el primer caso del hongo negro en Chile. Situación compleja ya que también se reportó la aparición de otra infección en el país denominada como el hongo verde.
Según el estudio entregado por la Universidad de Valparaíso, hasta el momento hay cinco casos. Los que se podrían aumentar a lo largo del país. En particular, este tipo de mucormicosis se agrava en pacientes que están graves por el coronavirus.
"Antes de la pandemia en nuestro país se describían esporádicamente algunos casos de mucormicosis y de aspergilosis pulmonar, porque se trata de infecciones provocadas por hongos invasores ubicuos, es decir, que se encuentran en todas partes. Pero casos asociados a pacientes con COVID-19 solo hemos tenido aspergilosis", precisó el director del Centro de Diagnóstico e Investigación de Enfermedades Infecciosas de la Universidad de Valparaíso, Rodrigo Cruz.
¿En qué consiste el hongo verde?
El hongo verde (Aspergillus fumigatus) está asociado al COVID-19 ya que se da en pacientes que se encuentran graves. Como se mencionó, son infecciones provocadas por hongos invasores ubicuos que se pueden encontrar en todos lados.
Su nombre se debe al color verde que tiene y las personas de más riesgo son pacientes diabéticos descompensados, inmunodeprimidos y oncohematológicos.
¿Cómo se diferencia del hongo negro?
Según explicaron los especialistas, la diferencia se da en el diagnóstico. "En el caso de personas con COVID-19, la infección por ´hongo verde' se diagnostica a través de cultivos o mediante la detección del antígeno (galactomanano) que libera. Mayoritariamente se da en pulmones y en pacientes que llevan varias semanas conectados a ventilación mecánica y bajo tratamiento de corticoides", explicó Cruz.
Sin embargo se recalcó que en Chile todavía no hay ningún caso del hongo negro, cuyos casos ya se confirman en India y Uruguay.
¿Qué tan grave es el hongo negro?
El especialista confirmó que la infección causada por este tipo de hongos son graves en sí y se asocian a una mayor mortalidad, dado que atacan a personas que ya se encuentran graves por alguna otra patología de base.
"La presencia de estos hongos por lo general ensombrece los pronósticos, en especial en casos de pacientes diabéticos descompensados, inmunodeprimidos y oncohematológicos que están con soporte ventilatorio. Afortunadamente, su incidencia es baja. Por lo tanto, la detección de estos hongos negros y verdes no es para alarmarse, pero si para tener en antecedente y seguir cuidándose", sentenció.
Te podría interesar:
- Bono IFE mayo: consulta fecha de pago, resultados y cuándo parten las postulaciones en junio
- Llegan 300 mil dosis de vacunas Cansino a Chile: solo requiere de una dosis
- Carabineros detuvo a constituyente electo por La Lista del Pueblo en Plaza Italia





